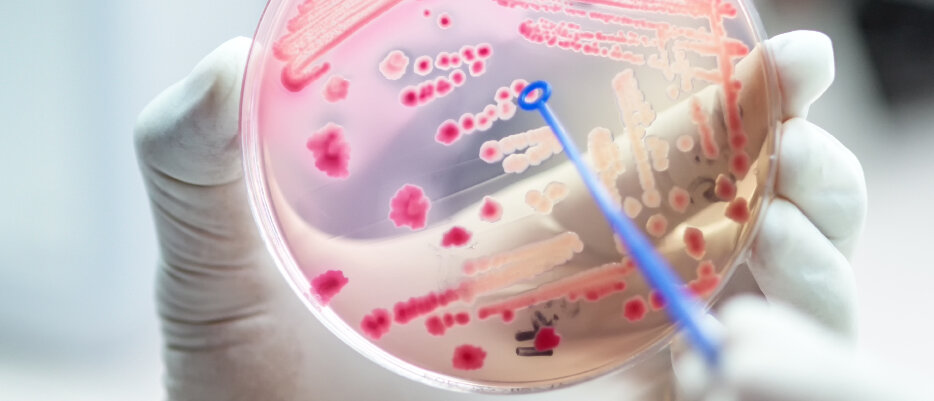

Reserveantibiotika
WENN NICHTS MEHR HILFT
Seite 1/1 4 Minuten
Durch jeden Einsatz von Antibiotika wird ein Selektionsdruck auf Bakterien ausgeübt. Die Erreger, die eine Resistenz gegenüber dem jeweiligen Antibiotikum entwickeln, können überleben und vermehren sich weiter. Bakterien, bei denen die wachsenden Resistenzzahlen besonders relevant sind, sind Escherichia coli, Klebsiella pneumonia, Pseudomonas aeruginosa, Staphylococcus aureus und Enterococcus faecium. Mittlerweile findet die Verbreitung global statt. In den vergangenen Jahren wurde in Deutschland viel getan, um die Resistenzlage zu verbessern. Durch Umsetzung intensiver Hygiene- und Screeningmaßnahmen auf multiresistente Erreger konnten die Nachweisraten zum Beispiel für Methicillin-resistente Staphylococcus aureus (MRSA) auf aktuell etwa ein Zehntel der Proben reduziert werden.
Der Anteil Vancomycin-resistenter Enterokokken (VRE) stieg dagegen leicht. „Bei der Bewertung der Resistenzsituation im zeitlichen Verlauf wurde eine Zunahme der Resistenz in Blutkulturen gegenüber Cephalosporinen der dritten Generation sowohl bei E. coli als auch bei K. pneumoniae beobachtet“, berichtet das Robert Koch-Institut. Besser sieht es bei den Carbapenemen aus, einer anderen Subgruppe der Betalactam-Antibiotika mit breitem Wirkspektrum, hier liegen die Resistenzraten sowohl für Escherichia coli als auch K. pneumoniae unter einem Prozent. Ursachen für steigende Resistenzen bei Bakterien liegen in der Verwendung von Antibiotika in der Tierhaltung, aber in großem Maße auch in der weltweit steigenden Mobilität und der großzügigen Verschreibung von Antibiotika. In den letzten Jahren hat es bei vielen Ärzten ein Umdenken gegeben; die Verordnungszahlen von Antibiotika sinken in Deutschland.
Auch in einigen Leitlinien, wie zum Beispiel in der S3-Leitlinie zur Behandlung der unkomplizierten Harnwegsinfektion, wird vor einem unangemessenen Antibiotikaeinsatz bestimmter Antibiotikaklassen (zum Beispiel Fluorchinolone und Cephalosporine der dritten Generation) gewarnt, um die Entwicklung von Resistenzen zu vermeiden. Der Druck vieler Patienten auf die Ärzte ist groß, auch bei banalen Infektionen ein Antibiotikum verordnet bekommen zu wollen. Hier können PTA und Apotheker wichtige Aufklärungsarbeit leisten, auf die Gefahr der Resistenzbildung hinweisen und Antibiotika-Pässe abgeben, in denen Patienten ihre Antibiotikaverordnungen dokumentieren.
Durch Aufklärungsarbeit und Antibiotika-Pässe können PTA und Apotheker den Kampf gegen Resistenzen unterstützen.
Vancomycin Als Glycopeptid-Antibiotikum hemmt Vancomycin den Aufbau der bakteriellen Zellwand. Die Zellwand hält dann dem osmotischen Druck nicht stand und platzt. Die Wirkung von Vancomycin ist bakterizid auf aerobe grampositive und anaerobe Keime wie Clostridium difficile. Vancomycin wird oral oder intravenös angewendet. Es ist zu beachten, dass Vancomycin nephrotoxische Wirkungen hat und deshalb die Nierenwerte bei längerer Behandlung, einer hohen Dosierung oder bei bereits bestehenden Nierenschäden engmaschig kontrolliert werden sollen.
Vancomycin hat die Indikation zur Behandlung von schweren Entzündungen der Herzinnenhaut (Endocarditis), Hirnhautentzündungen und entzündlichen Darmerkrankungen. Enterokokken sind grampositive Bakterien, die besonders im Darm vorkommen. Enterococcus faecium-Infektionen lassen sich nur schwer behandeln. Vancomycin oder Teicoplanin sind die Antibiotika der Wahl. Teicoplanin, ebenfalls ein Glykopeptid, ist für die parenterale Behandlung von komplizierten Haut- und Weichteilinfektionen, Herzentzündungen, Pneumonien und Knocheninfektionen zugelassen.
Linezolid Gegen vancomycinresistente Keime galt zunächst Linezolid als gute Waffe. Linezolid wirkt auf grampositive Keime bakteriostatisch, indem es selektiv die bakterielle Proteinbiosynthese durch Bindung an das bakterielle Ribosom hemmt. Es wird intravenös und oral angewendet. Mittlerweile existieren jedoch auch Vancomycin-resistente Enterokokken, die gegen Linezolid ebenfalls resistent sind. Linezolid wirkt außerdem gegen Staphylokokken und Streptokokken. Es ist zugelassen zur Behandlung von schweren Pneumonien und schweren Haut- und Weichteilinfektionen.
Nebenwirkungen sind Knochenmarkssuppression und Blutbildveränderungen. Linezolid hemmt reversibel die Monoaminooxidase, wirkt in den antimikrobiell angewandten Dosierungen jedoch nicht antidepressiv. Allerdings ist eine Erhöhung der Serotoninspiegel zu erwarten und als Wechselwirkung mit serotonergen Wirkstoffen zu beachten. Tedizolid wirkt aufgrund seiner Bindungseigenschaften auch beim linezolidresistenten Staphylococcus aureus und ist deutlich bakterizider als Linezolid.
Daptomycin Einen besonderen Wirkmechanismus hat Daptomycin. Es bildet Poren in der Zellmembran, durch die Ionen aus dem Zellinnern austreten können. Die Transportkanäle der Zellwand sind in ihrer Funktion gestört, Biosynthesevorgänge werden gehemmt und die Zelle wird abgetötet. Die bakerizide Wirkung ist nur auf grampositive Bakterien ausgerichtet. Das Haupteinsatzgebiet sind schwere Infektionen der Haut und Weichteile. Unter Daptomycin sind keine Wechselwirkungen über das Cytochrom-P450-System zu befürchten, allerdings ist das Risiko für Myopathien erhöht.
Resistenzbildung wird begünstigt durch:
+ Unkritischen Einsatz von Antibiotika
+ Antibiotikaverordnung ohne Erregerbestimmung
+ Zu niedrige Antibiotikakonzentration
+ Unvollständige Antibiotikaeinnahme
Ceftobirol und Ceftarolin Es gibt zwei neue Cephalosporine der fünften Generation. Sie haben eine Erweiterung des Wirkspektrums auch gegen MRSA. Sie wirken gegen grampositive Erreger und gegen einige gramnegative Bakterien, aber nicht Pseudomonas aeruginosa. Gegen Enterokokken und Listerien wirken sie nicht. Hauptindikationen sind komplizierte Haut- und Weichteilinfektionen, sowie Pneumonien und MRSA-Infektionen.
Kombinationen Relativ neu sind das β-Lactam-Antibiotikum Ceftazidim und der β-Lactamase-Inhibitor Avibactam. Zugelassen ist die Fixkombination zur Behandlung von komplizierten intraabdominellen Infektionen, im Krankenhaus erworbenen Pneumonien oder schweren Harnwegsinfektionen. Zudem ist der Einsatz bei Infektionen mit aeroben gramnegativen Keimen bei Erwachsenen möglich, wenn andere Therapieoptionen begrenzt sind. Die Kombination eröffnet ein breites Wirkspektrum.
Interessant ist, dass Avibactam selber kein Antibiotikum ist, sondern als Hemmstoff der β-Lactamasen verhindert, dass Ceftazidim abgebaut wird und so verstärkt wirkt. Ähnlich ist die Kombination Ceftolozan/Tazobactam einzuordnen. Diese Reserveantibiotika werden intravenös verabreicht. Als Nebenwirkungen treten Übelkeit und Erbrechen besonders häufig auf. Zu beachten sind auch Clostridium difficile assoziierte Diarrhöen. Dann muss die Therapie abgebrochen werden und eine Therapie gegen Clostridium difficile eingeleitet werden.
Den Artikel finden Sie auch in die PTA IN DER APOTHEKE 02/2020 ab Seite 24.
Dr. Katja Renner, Apothekerin